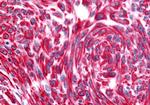
CHRM2 Antibody in Immunohistochemistry (Paraffin) (IHC (P))

Search
Invitrogen
CHRM2 Polyclonal Antibody
{{$productOrderCtrl.translations['antibody.pdp.commerceCard.promotion.promotions']}}
{{$productOrderCtrl.translations['antibody.pdp.commerceCard.promotion.viewpromo']}}
{{$productOrderCtrl.translations['antibody.pdp.commerceCard.promotion.promocode']}}: {{promo.promoCode}} {{promo.promoTitle}} {{promo.promoDescription}}. {{$productOrderCtrl.translations['antibody.pdp.commerceCard.promotion.learnmore']}}
产品信息
PA5-33428
种属反应
宿主/亚型
分类
类型
抗原
偶联物
形式
浓度
规格
纯化类型
保存液
内含物
保存条件
运输条件
RRID
靶标信息
Muscarinic cholinergic receptor 2 (CHRM2) is an Acetylcholine Receptor has been suggested to function as a presynaptic autoreceptor that inhibits acetylcholine release. The M2 receptor has also been suggested to mediate smooth muscle contractility. Alzheimer's disease (AD) involves selective loss of M2 subtype receptors in cortical and hippocampal regions of the human brain. Increase in M2 receptor heterozygosity has been associated with depression in women. The M2 receptor has been reported to be expressed in various regions of the brain including the cerebellum, cerebral cortex, hippocampus, medulla, striatum, and thalamus, and in lung and prostate.
仅用于科研。不用于诊断过程。未经明确授权不得转售。
篇参考文献 (0)
生物信息学
蛋白别名: 7TM receptor; acetylcholine receptor; acetylcholine receptor, muscarinic 2; AChR M2; cardiac muscarinic acetylcholine receptor; cholinergic receptor; cholinergic receptor, muscarinic 2; cholinergic receptor, muscarinic 2, cardiac; cytotransmitter gated ion channel; FLJ43243; G protein coupled receptor; M2 muscarinic acetylcholine receptor; M2-mAChR; m2AChR; MGC120006; MGC120007; muscarinic acetylcholine receptor 2; Muscarinic acetylcholine receptor M2; muscarinic M2 receptor; muscarinic receptor 2; muscarinic receptor m2; unnamed protein product
基因别名: AChR-M2; Acm2; Chrm-2; CHRM2; Gpm2; HM2; I79_007306; M2
UniProt ID: (Human) P08172, (Bovine) P41985, (Pig) P06199, (Mouse) Q9ERZ4, (Rat) P10980